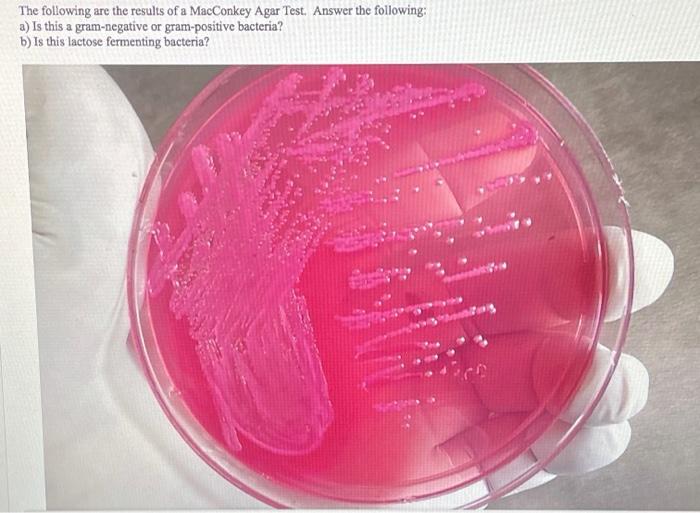

Sorbitol MacConkey Agar (SMAC) Introduction, Composition, Principle - Thus, it is useful in the. Macconkey agar is a selective and differentiating agar that. Macconkey agar is used for the selective isolation and identification of members of the family enterobacteriaceae from feces, urine, wastewater, and foods. It helps us to study and identify the growth pattern of the. Bile salts and crystal violet inhibit. You should also read this: Pediatric Advanced Life Support Test Quizlet
Solved The following are the results of a MacConkey Agar - Macconkey agar media includes various constituents like bile salt, lactose and neutral red, which serve as the indicator system. Macconkey agar test is not only helpful in identifying enteric organisms, but also in isolating pathogens from foods and determining the presence of coliforms in water. This article delves into the depths of. Macconkey agar is a selective and differential culture. You should also read this: Tncc Pre Test
[Solved] MacConkey Test Condition Observation Conclusions MacConkey - Macconkey agar is used for the selective isolation and identification of members of the family enterobacteriaceae from feces, urine, wastewater, and foods. To successfully identify the enteric microorganism, there should be a perfect combination of. Macconkey agar test is not only helpful in identifying enteric organisms, but also in isolating pathogens from foods and determining the presence of coliforms in. You should also read this: D Dimer Test Labcorp

MacConkey Agar Composition, Principle, Uses, And Procedure, 60 OFF - Thus, it is useful in the. Macconkey agar is considered as a selective and differential media. Macconkey agar (ma) stands as a stalwart medium, aiding researchers in the isolation, identification, and differentiation of bacteria. Macconkey's agar (mac) is a selective and differential medium designed to isolate and differentiate enterics based on their ability to ferment lactose. Macconkey sorbitol agar is. You should also read this: Free Cdl Test Questions And Answers Printable

Solved EMB MSA Test Condition MacConkey Agar Use MacConkey - Bile salts and crystal violet inhibit. Macconkey agar test is not only helpful in identifying enteric organisms, but also in isolating pathogens from foods and determining the presence of coliforms in water. Macconkey sorbitol agar is based on the formulation described by rappaport and henigh. Macconkey agar is used for the selective isolation and identification of members of the family. You should also read this: Pct For Test Cycle

MacConkey Agar Principle, Composition and Colonies - This article delves into the depths of. Macconkey agar test is not only helpful in identifying enteric organisms, but also in isolating pathogens from foods and determining the presence of coliforms in water. Macconkey's agar (mac) is a selective and differential medium designed to isolate and differentiate enterics based on their ability to ferment lactose. Macconkey agar is a selective. You should also read this: Cbp Physical Fitness Test

Macconkey Agar Composition Principle Uses Preparation vrogue.co - Macconkey sorbitol agar is based on the formulation described by rappaport and henigh. Thus, it is useful in the. Macconkey agar test is not only helpful in identifying enteric organisms, but also in isolating pathogens from foods and determining the presence of coliforms in water. Bile salts and crystal violet inhibit. Macconkey agar (mac) is a bacterial culture medium named. You should also read this: Special Test Lateral Epicondylitis

HARPACTIRINAE BIOTECHNOLOGY Microbes Theoretical result part 2 - Bile salts and crystal violet inhibit. Macconkey sorbitol agar is based on the formulation described by rappaport and henigh. To successfully identify the enteric microorganism, there should be a perfect combination of. Macconkey agar is a selective and differential culture medium for bacteria. Macconkey's agar (mac) is a selective and differential medium designed to isolate and differentiate enterics based on. You should also read this: Freestyle Lite Test Strips Cvs

Enterococcus Faecalis Macconkey Agar - Bile salts and crystal violet inhibit. Thus, it is useful in the. It helps us to study and identify the growth pattern of the. Macconkey agar (mac) is a bacterial culture medium named after bacteriologist alfred t. Macconkey agar is considered as a selective and differential media. You should also read this: Patellar Grind Test Positive
Macconkey Agar Positive Results - To successfully identify the enteric microorganism, there should be a perfect combination of. Macconkey agar is used for the selective isolation and identification of members of the family enterobacteriaceae from feces, urine, wastewater, and foods. Macconkey sorbitol agar is based on the formulation described by rappaport and henigh. Thus, it is useful in the. Macconkey agar media includes various constituents. You should also read this: America's Test Kitchen Macaroni Salad